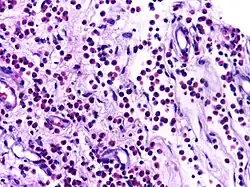
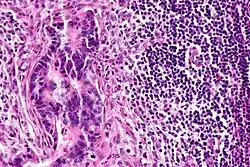

Open Pathology Project
Open Pathology Education Project aims at providing open pathology educational resources for students and educators. This project involves developing, curating and sharing pathology related educational material under CC licenses. Here is the list of topics under the scope of this project. This page contains 87 topic areas.
| Image | Article | Description | Commons histopathology category | Structured data item |
|---|---|---|---|---|
 |
Neutrophils | Micrograph showing neutrophils in acute inflammation. | Category: Neutrophils | Neutrophil |
 |
Plasma cells | Plasma cell showing eccentrically placed round nucleus with cart wheel like chromatin. | Category: Plasma cells | Plasma cell |
|
Eosinophils | Micrograph showing low power view of Eosinophils. | Category: Eosinophils | Eosinophil |
 |
Lymphocyte | Micrograph showing lymphocytes in caseating granuloma. | Category: Lymphocytes | Lymphocyte |
 |
Fibroblasts | Fibroblasts in intestinal pneumonia | Category: Fibroblasts | Fibroblast |
 |
Foam cells | Histopathology of cholesterolosis of the gallbladder, with annotated foam cell | Category: Foam cell | Foam cell |
 |
Macrophages | Lung showing congestion with plenty of alveolar macrophages containing phagocytosed brownish granular hemosiderin pigment. | Category: Macrophages | Macrophage |
.jpg) |
Langhans cells | Langhans giant cell in the centre of a non-caseating granuloma. | Category: Langhans giant cells | Langhans giant cell |
 |
Foreign body giant cells | Micrograph showing a foreign body engulfed by a giant cell. | Category: Foreign body giant cell | Foreign body giant cell |
 |
Granulation tissue | Micrograph showing proliferating capillaries, fibroblasts and acute inflammatory cells. | Category: Histopathology of granulation tissue | Granulation tissue |
 |
Foreign body granuloma | Granulomatous reaction to keratin characterized by foreign body giant cells and chronic inflammatory cells. | Category: Histopathology of foreign body granuloma | Foreign body granuloma, silicone granuloma |
 |
Tuberculous granuloma | Caseating granulomatous lesion with areas of amorphous granular eosinophilic necrotic debris known as caseation (on the right half) bordered by collections of epitheloid cells, Langhan giant cells and lymphocytes. | Category: Histopathology of tuberculous granuloma | Tuberculous granuloma |
 |
Fat necrosis | Breast lump showing an area of fat necrosis showing shadowy outlines of necrotic adipocytes surrounded by an inflammatory reaction with cholesterol clefts. | Category: Histopathology of liponecrosis | Liponecrosis |
 |
Calcinosis cutis | Multiple amorphous basophilic calcium deposits in the dermis. | Category: Histopathology of calcinosis cutis | Calcinosis cutis |
 |
Hemochromatosis liver | Micrograph of hemochromatosis liver showing hepatocytes with coarse golden yellow granules of hemosiderin within the cytoplasm. These granules stain with Prussian blue stain. | Category: Histopathology of hemochromatosis | hereditary hemochromatosis |
 |
Caseous necrosis | Caseating granulomatous lesion with areas of amorphous granular eosinophilic necrotic debris known as caseation (on the right half) bordered by collections of epitheloid cells, Langhan giant cells and lymphocytes. | Category: Histopathology of caseous necrosis | caseous necrosis |
 |
Fatty change in liver | Hepatic parenchymal cell cytoplasm containing clear vacuoles containing fat of varying sizes, displacing the nucleus towards the periphery. | Category: Lipid steatosis | steatosis |
 |
Carcinoma in situ | CIN-III (HSIL) showing diffuse severe atypia with loss of maturation involving full thickness of epithelium with intact basement membrane. | Category: Histopathology of carcinomas in situ | Carcinoma in-situ |
|
Lymph node metastasis | Lymph node showing metastases from colorectal carcinoma | Category: Lymph node metastases | Lymph node metastasis |
 |
Fibroadenoma | A well circumscribed lesion showing proliferation of intralobular stroma compressing and distorting the epithelium. | Category: Histopathology of breat fibroadenomas | Fibroadenoma |
 |
Tumor giant cell | Malignant neoplasm showing marked anaplasia. Note the marked nuclear pleomorphism, bizarre cells and tumor giant cells. | Category: Histopathology of giant cell tumors | Giant cell tumor |
 |
Capillary hemangioma | Micrograph showing capillary hemangioma of skin. | Category: Histopathology of capillary hemangioma | Capillary hemangioma |
_10x.jpg) |
Lepromatous leprosy | Skin biopsy showing epidermal atrophy and multiple dermal infiltrates. | Category: Histopathology of leprosy | Leprosy |
_-_1.jpg) |
Tuberculoid leprosy | Skin biopsy showing multiple peri-appendageal granulomas. | Category: Histopathology of leprosy | Leprosy |
 |
Tuberculous lymphadenitis | Caseating granulomatous lesion with areas of amorphous granular eosinophilic necrotic debris known as caseation (on the right half) bordered by collections of epitheloid cells, Langhan giant cells and lymphocytes. | Category: Histopathology of tuberculous lymphadenitis | Tuberculous lymphadentis |
.jpg) |
Tuberculosis of intestine | The lamina propria is stuffed with wall-to-wall histiocytes. This Kinyoun carbolfuchsin stain shows innumerable acid-fast bacilli | Category: Histopatology of gastrointestinal tuberculosis | Gastrointestinal tuberculosis |
 |
Helminth in appendix | Micrograph showing lumen of appendix and cut section of pin worm. | Category: Histopathology of appendix with Enterobius vermicularis | Parasitic helminthiasis infectious disease |
 |
Chromoblastomycosis | Micrograph of chromoblastomycosis showing sclerotic bodies in dermis. | Category: Histopathology of chromoblastomycosis | Chromoblastomycosis |
 |
Amoebiasis | Colonic biopsy showing trophozoite of Entamoeba Histolytica with ingested red blood cells. | Category: Histopathology of amoebiasis | Amoebiasis |
 |
Rhinosporidiosis | Section of a polyp containing Rhinosporidium seeberi | Category: Histopathology of rhinosporidiosis | Rhinosporidiosis |
.jpg) |
Filarial lymphadenitis | Micrograph showing section of an adult filarial worm. Surrounding tissue shows dense infiltration of eosinophils. | Category: Histopathology of filariases | filariasis |
 |
Reactive hyperplasia of lymph node | Histopathology of a reactive lymph node by the cystic duct in a case of cholecystitis. | Category: Reactive hyperplasia of lymph node | Reactive hyperplasia |
 |
Diffuse B-cell lymphoma | Lymph node FNA specimen showing diffuse large B cell lymphoma. | Category: Histopathology of diffuse large B cell lymphoma | Diffuse large B-cell lymphoma |
 |
Follicular lymphoma | Micrograph showing a small B-cell lymphoma compatible with follicular lymphoma. H&E stain. | Category: Histopathology of follicular lymphoma | Follicular lymphoma |
 |
Hodgkin's lymphoma | Micrograph of a lymph node in Hodgkin's lymphoma with the characteristic Reed-Sternberg cell. RS cell is a large cell with abundant amophophilic cytoplasm and binucleate mirror image nuclei. Each nucleus contains an acidophilic nucleolus surrounded by a halo. | Category: Histopathology of Hodgkin's lymphoma | Hodgkin's lymphoma |
 |
Congestive hepatopathy (CVC liver) | Micrograph showing chronic venous congestion of liver | Category: Histopathology of chronic venous congestion of liver | Congestive hepatopathy of liver |
 |
Chronic venous congestion of spleen | Micrograph showing chronic venous congestion of spleen. Sinusoids are dialated. Organized foci of old hemorrhage seen as areas of fibrosis containing brown pigment (hemosiderin). | Category: Histopathology of chronic venous congestion of spleen | Chronic venous congestion of spleen |
.jpg) |
Cavernous hemangioma | Histopathological image reprsenting a cavernous hemangioma of the liver. | Category: Histopathology of cavernous liver hemangioma | Cavernous hemangioma |
| Atherosclerosis | Atherosclerosis showing extracellular lipid accumulation and foam cells. | Category: Histopathology of atherosclerosis | Atherosclerosis | |
 |
Emphysema | Micrograph of empysema lung showing dialated, large alveoli separated by thin septa. Some septae are ruptured and appear to be floating in the alveloar spaces. Grossly emphysematous lung appears pale and voluminous. | Category: Histopathology of pulmonary emphysema | Emphysema |
 |
Squamous cell carcinoma of lung | Micrograph of squamous Cell Carcinoma Lung. A lobule of polygonal squamous cells with moderate amount of eosinophilic cytoplasm and hyperchromatic nuclei are seen. The islands show abnormal keratinization in the form of epithelial pearls in the centre. These epithelial pearls are whorls or eddies of malignant cells with pink keratin in the centre. | Category: Histopathology of squamous cell carcinoma of the lung | Squamous cell carcinoma of lung |
 |
Bronchoalveolar carcinoma | Lepidic pattern of growth of tumor cells along the alveolar wall resembling butterfly sitting on fence. Normal alveoli is seen towards right side. | Category: Histopathology of bronchio-alveolar carcinoma | Bronchio-alveolar carcinoma |
 |
Pulmonary tuberculosis | Pulmonary tuberculosis characterized by granulomatous inflammation with necrotizing epithelioid granulomas. | Category: Histopathology of pulmonary tuberculosis | Pulmonary tuberculosis |
.jpg) |
Aspergilloma | This ectatic bronchus is filled with a colony of Aspergillus. The organisms are confined to the lumen of the bronchus and do not invade surrounding tissues. | Category: Histopathology of pulmonary aspergilloma | Aspergilloma |
 |
Small cell carcinoma of lung | Micograph of small Cell Carcinoma Lung. The tumor appears blue because the malignant epithelial cells are small with scanty cytoplasm, nuclei shows finely granulated chromatin. Cells are seen in clusters. There is nuclear overlapping with moulding and crushing. | Category: Histopathology of small cell lung cancer | Small cell lung cancer |
 |
Pneumonia | Lung tissue showing numerous neutrophils with minimal exudates in the alveolar space with septal wall congestion. | Category: Histopathology of pneumonia | Lobar pneumonia |
.jpg) |
Aspiration pneumonia | Lung tissue where alveoli contain hemosiderin-laden macrophages and occasional multinucleate giant cells as well as red blood cells. | Category: Histopathology of aspiration pneumonia | Aspiration pneumonia |
 |
Adenocarcinoma colon | Micrograph of carcinoma colon showing malignant glands.Nuclei are small and vesicular, located at the bottom of the cell. The cells show increased nucleocytoplasmic ratio. | Category: Histopathology of colorectal adenocarcinoma | Colorectal carcinoma |
 |
Chronic gastric ulcer | Acute stress ulcer of stomach in erosive gastritis. | Category: Histopathology of gastritis | Gastritis |
 |
Adenocarcinoma stomach | Micrograph of carcinoma stomach. The glands are seen infiltrating the muscle layer. The neoplastic cells are arranged in cords and in glandular pattern. The cells show dysplastic features. Signet rings with nucleus pushed to the periphery are seen in some types of adenocarcinoma. | Category: Histopathology of adenocarcinoma stomach | Adenocarcinoma of stomach |
 |
Squamous cell carcinoma of the skin | Well-differentiated squamous cell carcinoma skin showing malignant cells with mild atypia resembling normal squamous epithelial cells with intercellular bridges, individual cell keratinisation and nests of keratin pearls. | Category: Histopathology of squamous cell carcinoma of the skin | Squamous cell carcinoma |
 |
Pleomorphic adenoma | Micrograph of Pleomorphic Adenoma of Salivary gland. The section shows a cellular area interspersed with islands of lighter stained bluish myxoid tissue. The cellular area is the epithelial element and is composed of cells arranged in sheets and trabeculae. The myxoid areas may resemble cartilage and represent the mesenchymal element. | Category: Histopathology of pleomorphic adenoma | Pleomorphic adenoma |
 |
Cirrhosis | Micrograph of liver showing nodules of parenchymal liver cells engulfed by broad bands of fibrous tissue. The liver has lost its normal architecture. | Category: Histopathology of alcoholic cirrhosis | Liver cirrhosis |
 |
Fatty liver | Hepatic parenchymal cell cytoplasm containing clear vacuoles containing fat of varying sizes, displacing the nucleus towards the periphery. | Category: Lipid steatosis | steatosis |
 |
Serous cystadenoma | Histopathology of serous cystadenoma, with admixed scattered ciliated cells. This case closely resembles normal surface endometrial epithelium of the uterus | Category: Histopathology of ovarian serous cystadenoma | Ovarian cystadenoma |
 |
Mucinous cystadenoma | Micrograph showing Mucinous Cystadenoma of ovary. The cyst wall is lined by tall columnar epithelium and filled with mucin. | Category: Histopathology of mucinous cystadenoma | Mucinous cystadenoma |
 |
Dysgerminoma | Dysgerminoma characterized by uniform cells resembling primordial germ cells separated by fibrous septa with lymphocytes. | Category: Histopathology of ovarian dysgerminoma | Ovarian dysgerminoma |
 |
Vesicular mole | Micrograph of vesicular mole showing oedematous chorionic villus with circumferential proliferation of trophoblasts. | Category: Histopathology of chorionic villi | chorionic villi |
.jpg) |
Products of gestation | Micrograph showing products of conception. Chorionic villi and decidual tissue are seen. | Category: Histopathology of products of conception | products of conception |
 |
Benign cystic teratoma | Micrograph of Teratoma Ovary showing areas of cartilage, mucous glands, squamous epithelium and hair follicle. | Category: Histopathology of mature teratoma of ovary | teratoma |
 |
Seminoma testis | Micrograph of seminoma testes showing lobules of uniform cells separated by delicate septae of fibrous tissue. These cells can have a distinct outline with clear cytoplasm. The nuclei are large, with central prominent nucleolus. | Category: Histopathology of testicular seminoma | seminoma |
 |
Endometrium | Micrograph showing proliferative phase of endometrium. | Category: Histology of endometrium | endometrium |
 |
Leiomyoma uterus | Micrograph of leiomyoma uterus showing bundles of smooth muscle cells of uniform size and shape. The cells are spindle shaped with oval nucleus. | Category: Histopathology of uterine fibroids | Leiomyoma |
.jpg) |
Squamous cell carcinoma of cervix | Invasive Squamous Carcinoma of the Cervix. Cold Knife Cone. | Category: Histopathology of squamous cell carcinoma of the cervix | Invasive squamous carcinoma of cervix |
 |
Cystic hyperplasia of endometrium | Micrograph showing cystic hyperplasia of endometrium. Cystically dialated glands are lined by proliferative type of epithelium. Stroma also resembles proliferative phase. No atypia is seen in the cells. | Category: Histopathology of hyperplasia endometrium | Cystic hyperplasia |
 |
Neuroblastoma | Histopathology specimen of neuroblastoma showing Homer Wright rosettes (HE stain) | Category: Histopathology of neuroblastoma | Neuroblastoma |
| Nephroblastoma | Adult Wilm's tumor showing tubular pattern resembling pseudo-rosettes at places. | Category: Histopathology of Wilm's tumor | Wilm's tumor | |
 |
Retinoblastoma | This retinoblastoma has characteristic Flexner-Wintersteiner rosettes with circular alignment of short columnar cells around a central lumen. | Category: Histopathology of retinoblastoma | Retinoblastoma |
 |
Osteoclastoma | The micrographs show the characteristic giant cells with nuclei that have a similar appearance to the surrounding (mononuclear) cells. | Category: Histopathology of giant cell tumor of bone | Giant cell tumor |
 |
Osteosarcoma | Small cell osteosarcoma, like other osteosarcomas has osteoid, the extracellular organic component of bone. On H&E stained sections, osteoid has a pink, homogeneous appearance and surrounds osteoblasts or osteosarcoma cells. | Category: Histopathology of osteosarcoma | Osteosarcoma |
 |
Plasmacytoma | Plasma cell showing eccentrically placed round nucleus with cart wheel like chromatin. | Category: Histopathology of plasmacytoma | Plasmacytoma |
.jpg) |
Osteochondroma | Perichondrium covering the cartilage cap, which merged into the underlying spongiosa. | Category: Histopathology of osteochondroma | osteochondroma |
 |
Hashimoto's thyroiditis | Hashimoto's thyroiditis with lymphoid infiltration. | Category: Hashimoto's thyroiditis with lymphoid infiltration | Hashimoto's thyroiditis |
 |
Papillary carcinoma thyroid | The phenomenon of orphan Anne eyes in papillary thyroid cancer. | Category: Histopathology of thyroid papillary carcinoma | papillary carcinoma |
| Nodular colloid goitre | Histopathology of multinodular toxic goiter, showing normal thyroid follicles with calcification but no psammoma bodies in low magnification and no atypia in higher magnification. | Category: Histopathology of goitres | goiter | |
 |
Glioblastoma | Biopsy specimen of a Glioblastoma showing extensive cell pleomorphism | Category: Histopathology of glioblastoma | glioblastoma |
 |
Meningoma | Concentrically calcified basophilic structure in the centre of the field in a meningioma. | Category: Histopathology of meningoma | meningoma |
 |
Fibrocystic disease of breast | Intermediate magnification micrograph of fibrocystic change of the breast with apocrine metaplasia. | Category: Histopathology of fibrocystic breast changes | fibrocystic breast |
 |
Infiltrative ductal carcinoma | Atypical cells with moderate amount of eosinophilic cytoplasm and round to oval dark nucleus with moderate pleomorphism (Papanicolaou, 400X) | Category: Histopathology of invasive carcinoma of no special type | invasive breast carcinoma |
 |
Fibroadenoma | A well circumscribed lesion showing proliferation of intralobular stroma compressing and distorting the epithelium. | Category: Histopathology of breast fibroadenomas | fibroadenoma |
 |
Phyllodes tumor | Photomicrograph of a malignant phyllodes tumour. Note stromal cellularity and mitotic figures. | Category: Histopathology of cystosarcoma phyllodes | Phyllodes tumor |
 |
Lipoma | Micrograph of a lipoma showing fat cells. | Category: Histopathology of lipomas | Lipoma |
.jpg) |
Basal cell carcinoma | Surgical excision biopsy specimen showing histopathology of basal cell carcinoma. | Category: Histopathology of basal cell carcinoma | Basal cell carcinoma |
 |
Malignant melanoma | Malignant spindle cell neoplasm, showing numerous mitotic figures, including atypical tripolar mitotic figure, in the centre. | Category: Histopathology of melanoma | Malignant melanoma |
 |
Squamous papilloma | Micrograph showing squamous cell papilloma of the tongue. | Category: Histopathology of squamous cell carcinoma | Squamous papilloma |
 |
Renal cell carcinoma | Micrograph of clear cell renal cell carcinoma showing cells with clear cytoplasm, typically arranged in nests and nuclear atypia. | Category: Histopathology of renal cell carcinoma | Renal cell carcinoma |
| Cresenteric glomerulonephritis | Photomicrograph of the renal biopsy showing prominent fibrocellular crescent formation and moderate mesangial proliferation in a glomerulus. | Category: Histopathology of glomerulonephritis | glomerulonephritis | |
| Transitional cell carcinoma | Histopathology of transitional carcinoma of the urinary bladder. | Category: Histopathology of transitional cell carcinoma | Urothelial carcinoma |
Accessing structured data
Histopathology images on Wikimedia Commons belonging to the above disease conditions have now been tagged with structured data. You can access these images by querying on Commons SPARQL query service. The query service has a backlog of about two months, so newly added structured data are cannot be queried using this service.